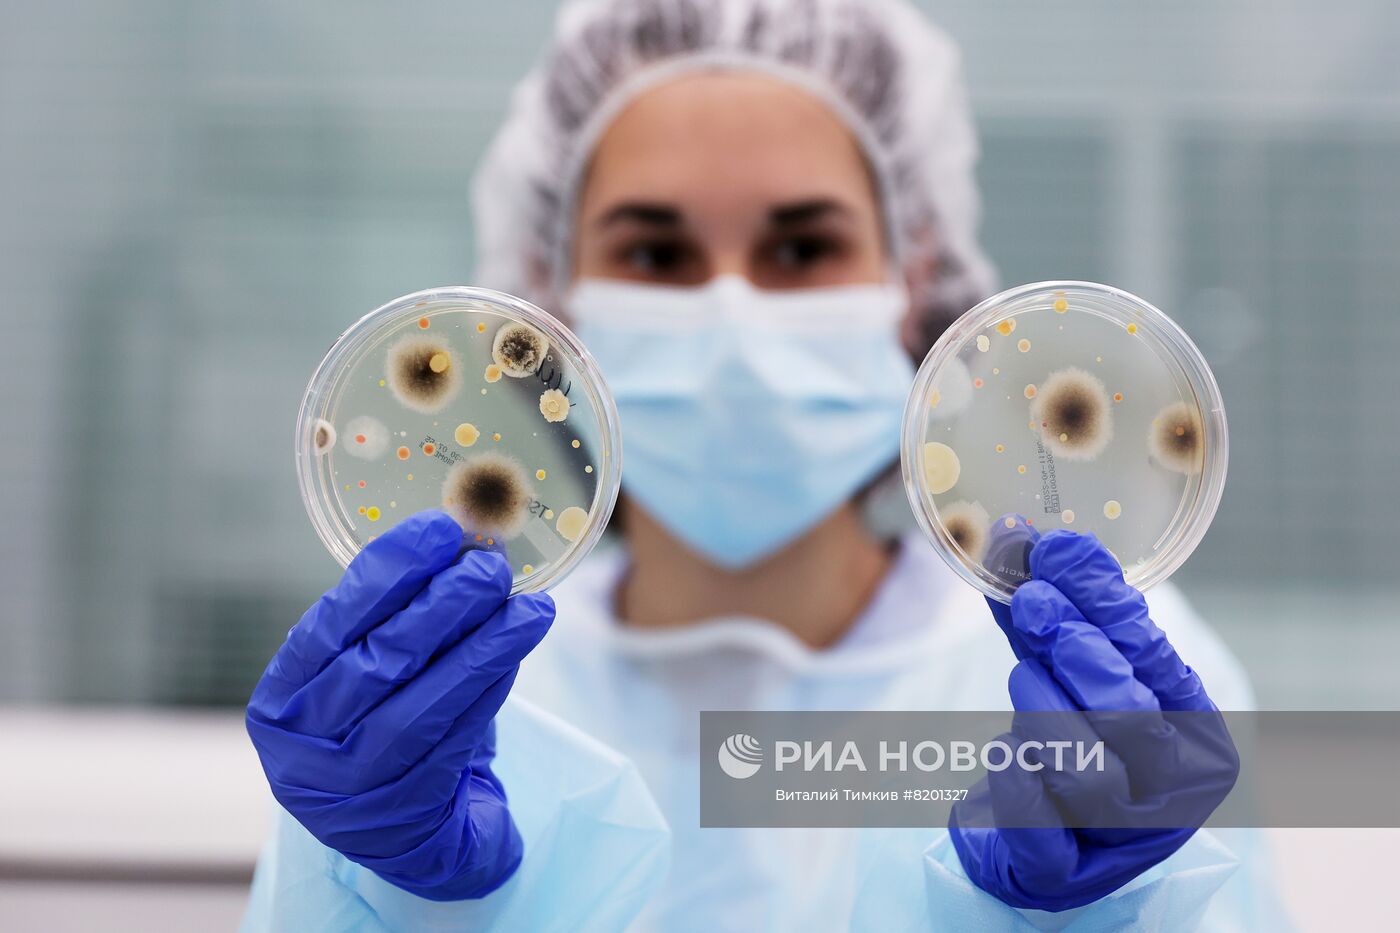
Парфюмерно-косметическая компания АО "Арнест"

Сотрудница микробиологической лаборатории компании "Арнест" в Невинномысске.
- Категории: Экономика, бизнес, финансы
- Место: Невинномысск, Россия
- Дата события: 26.05.2022
- Дата поступления: 27.05.2022
- Автор: Виталий Тимкив
- Кредит: РИА Новости
- Источник: РИА Новости
- Оригинал: Цифра
- Формат: JPEG, 4980x3320px, 8.1Mb
- Job-ID: 68cbdc25e752294c